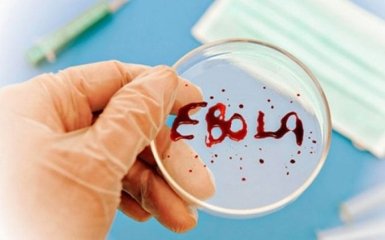
Винайдено вакцину від однієї з найстрашніших хвороб

Учені-медики змогли створити ефективну вакцину проти однієї з найбільш небезпечних хвороб - смертельного вірусу Ебола.
Про це заявили у Всесвітній організації охорони здоров'я, передає ONLINE.UA з посиланням на Радіо Свобода.
За даними ВООЗ, проведена в Гвінеї експертиза підтвердила високу ефективність експериментальної вакцини rVSV-ZEBOV.
Цим препаратом були щеплені понад п'ять тисяч осіб, які перебували в тісному контакті з хворими. Після цього протягом 10 днів спостереження не було зафіксовано жодного нового випадку захворювання.
Читайте також: Скажи їм, що ти мій ельф номер один: мережу вразила історія смерті хлопчика на руках у Санти
Нагадаємо, в 2014 році стався спалах цього смертельно небезпечного захворювання, і до березня 2016 роки від вірусу Ебола померли 11 316 чоловік із 28 639 заражених.
Найбільше були вражені країни Західної Африки.
Хвороба, яку викликає вірус Ебола, призводить до лихоманки та сильного болю, блювоти і проносу, порушення функції печінки і нирок і, в деяких випадках внутрішніх і зовнішніх крововиливів. Протягом тижня-двох настає смерть майже у половини хворих.
Дієвих вакцин і лікування досі не існувало. Передається вірус, як вважають, тільки шляхом фізичного контакту з хворими або з продуктами їх життєдіяльності.
Як повідомляв ONLINE.UA, одна з останніх смертей від Ебола була зафіксована в африканському Сьєрра-Леоне.
Based on your browser and language settings, you might prefer the English version of our website. Would you like to switch?